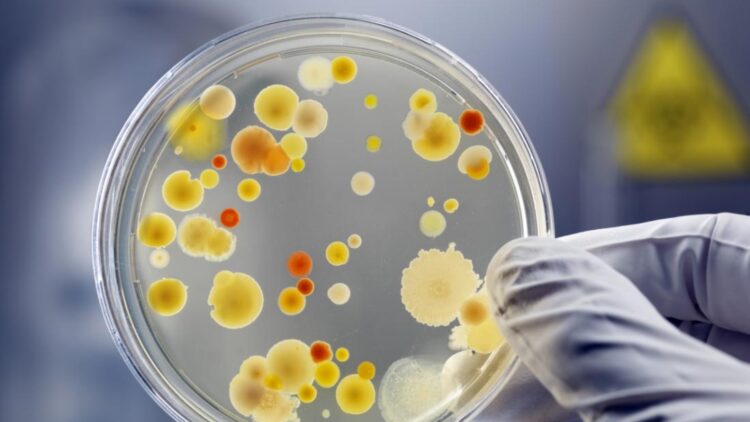
It's official—scientists have revived bacteria from 5,000 years ago and believe it could help fight superbugs—it could combat superbugs, and the risk is concerning

Scientists have discovered a bacteria frozen for 5,000 years in the Scărișoara Ice Cave. This tiny organism, called Psychrobacter SC65A.3, could help us fight antibiotic-resistant bacteria, also known as superbugs. However, it also has some risks since it’s resistant to many modern antibiotics.
The research was led by a team of scientists from the Institute of Biology Bucharest (IBB) and published in Frontiers in Microbiology. This study shows both the potential benefits and the risks of microbes preserved in frozen environments for thousands of years. So, let’s learn more about this research.
Where does this bacteria live?
The bacteria was extracted from the deep layer of ice in the Scărișoara Ice Cave by drilling a 25-meter (82-foot) ice core from an area called the Great Hall, and they carefully isolated different bacteria preserved in the ice.
Because the environment is extremely cold, the microbes evolved unique traits to survive. These adaptations could be useful in developing new antibiotics or other biotechnological applications.
Why is Psychrobacter SC65A.3 especial?
Bacteria are everywhere and they are constantly evolving. This old Psychrobacter SC65A.3 shows how microbes have been playing a natural “cat-and-mouse” game with antibiotics for millions of years. Some species in the Psychrobacter genus can cause infections, but many are harmless and adapted to survive in extreme cold. So, let’s see its two very different properties:
- It can be dangerous: it is resistant to multiple modern antibiotics used to treat infections of the lungs, skin, blood, and more. It carries over 100 genes that allow it to survive antibiotic treatments.
- It’s helpful: despite its resistance, the bacteria can inhibit the growth of several major superbugs. It also produces enzymes and compounds with potential for biotechnology and medicine.
Basically, this means that Psychrobacter SC65A.3 could help us create new antibiotics, but if released to the environment, it could share its resistant genes with modern bacteria making infection treatments more difficult.
Cristina Purcarea, a microbiologist at the IBB, warns:
“If melting ice releases these microbes, these genes could spread to modern bacteria, adding to the global challenge of antibiotic resistance. On the other hand, they produce unique enzymes and antimicrobial compounds that could inspire new antibiotics and biotechnological innovations.”
How they studied the bacteria
To better understand Psychrobacter SC65A.3, researchers:
- Collected ice cores from the cave.
- Isolated bacterial strains in the laboratory.
- Used genome sequencing to identify genes responsible for surviving the cold and producing antimicrobial compounds.
This analysis showed the bacteria can be both a benefit and a risk. Its genes could lead to new treatments, but if uncontrolled, could also worsen antibiotic resistance.
The future
Developing new antibiotics from Psychrobacter SC65A.3 will take some time… However, this research offers important lessons for us and scientists:
- It helps understand how bacteria survive extreme conditions.
- It shows how resistant genes can pass between species.
- It provides opportunities for biotechnological innovations, including new medicines and industrial enzymes.
The study encourages more research into microorganisms frozen for thousands of years. Isn’t it great that these microbes give scientists a glimpse into the ancient past while also offering potential solutions for modern health challenges?
So…
Next time you think about bacteria, remember that some are more than just a threat, they’re opportunities. We live in a world where we have the chance to stay curious, stay informed, and appreciate how science gives us tools to face invisible challenges that affect everyone, everywhere.